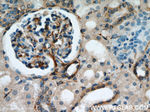
SEPT11 Antibody in Immunohistochemistry (Paraffin) (IHC (P))

Search
Proteintech
SEPT11 Polyclonal Antibody
{{$productOrderCtrl.translations['antibody.pdp.commerceCard.promotion.promotions']}}
{{$productOrderCtrl.translations['antibody.pdp.commerceCard.promotion.viewpromo']}}
{{$productOrderCtrl.translations['antibody.pdp.commerceCard.promotion.promocode']}}: {{promo.promoCode}} {{promo.promoTitle}} {{promo.promoDescription}}. {{$productOrderCtrl.translations['antibody.pdp.commerceCard.promotion.learnmore']}}
产品信息
14672-1-AP
种属反应
已发表种属
宿主/亚型
分类
类型
抗原
偶联物
形式
浓度
规格
纯化类型
保存液
内含物
保存条件
运输条件
产品详细信息
Immunogen sequence: MAVAVGRPS NEELRNLSLS GHVGFDSLPD QLVNKSTSQG FCFNILCVGE TGIGKSTLMD TLFNTKFESD PATHNEPGVR LKARSYELQE SNVRLKLTIV DTVGFGDQIN KDDSYKPIVE YIDAQFEAYL QEELKIKRSL FNYHDTRIHA C (1-150 aa encoded by BC063615)
靶标信息
SEPT11 belongs to the conserved septin family of filament-forming cytoskeletal GTPases that are involved in a variety of cellular functions including cytokinesis and vesicle trafficking.
仅用于科研。不用于诊断过程。未经明确授权不得转售。
生物信息学
蛋白别名: epididymis secretory sperm binding protein; septin 6; Septin-11; unnamed protein product
基因别名: 6230410I01Rik; AW548875; D5Ertd606e; SEPT11; Sept6; Septin-11; SEPTIN11
UniProt ID: (Human) Q9NVA2, (Rat) B3GNI6, (Mouse) Q8C1B7
Entrez Gene ID: (Human) 55752, (Rat) 305227, (Mouse) 52398